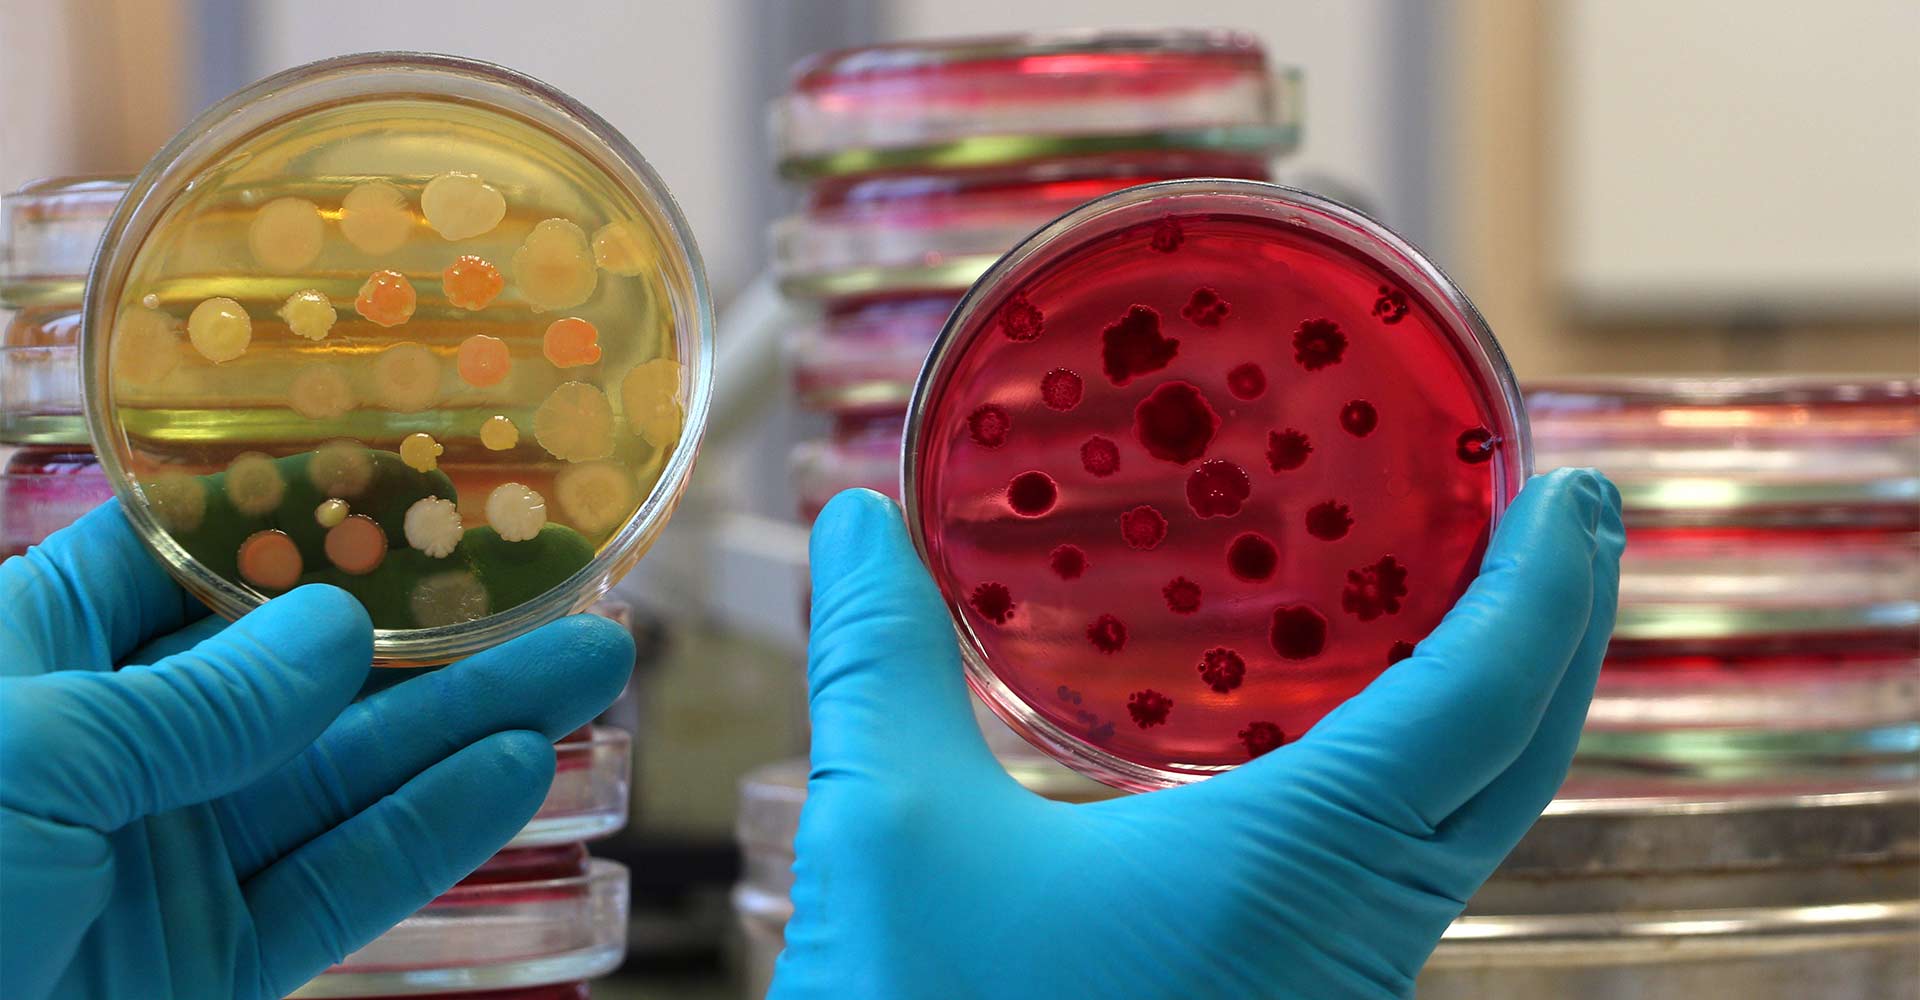

New Zealand Food Safety Science And Research Centre
Ruakura Conference Centre Hamilton. New Zealand Food Safety Science Research Centre newsletter issue 3 by FPSCANZ on 23042018 NZFSSRC.
It is a virtual centre that will see the best scientists from around the country collaborating on.
.jpg)
New zealand food safety science and research centre. Our science makes sure that we can produce nutritious tasty food now and for future generations. New Zealand Food Safety Science and Research Centre. We understand what consumers want and apply our knowledge in the lab and field to create new foods with great nutrition and that appeal to consumers whether they want novel colours longer shelf life or the perfect food for eating on the go.
We recognise the importance of involving all stakeholders together throughout the lifetime of the Centre. Science and Innovation Food Safety Science and Innovation Minister Steven Joyce and Food Safety Minister Jo Goodhew today launched the New Zealand Food Safety Science and Research Centre at Massey University in Palmerston North. We will start by providing regular updates as we.
Enter your email and click subscribe. The New Zealand Food Safety Science and Research Centre was launched yesterday in Palmerston North. Please contact Us for information.
A New Zealand Food Safety Science and Research Centre has recently opened at the Manawatu campus of Massey University in Palmerston North. 64 6 951 6355. Award recipients will be announced Wednesday 7th July.
New Zealand Food Safety Science and Research Centre NZFSSRC has released an updated version of its COVID-19 food safety review report. New Zealand Food Safety Science and Research Centre Newsletter The purpose of this newsletter is to provide you with a brief update on progress with the establishment of the New Zealand Food Safety Science and Research Centre the Centre. Five workshops were held meat and dairy in Wellington horticulture and processing and manufacturing in Auckland and seafood in Nelson.
The centre will ensure delivery of excellent food safety science and research while also minimising the risks of foodborne illness and maximising economic. Establishing a New Zealand centre of food safety science and research is one of the 29 recommendations from the Government Inquiry into the Whey Protein Concentrate WPC Contamination Incident released in December last year. Science and Innovation Minister Steven Joyce and Food Safety Minister JoGoodhew today launched the New Zealand Food Safety Science and Research Centre at Massey University in Palmerston North.
2 Nov 2021 845 AM. We will start by. A partnership between the government industry organisations and research institutions the centres role is to promote coordinate and deliver food safety science and research for all of New Zealand.
Apply to join NZFSSRC. Establishing a New Zealand centre of food safety science and research is one of the 29 recommendations from the Government Inquiry into the Whey Protein Concentrate WPC. New Zealand Food Safety Science and Research Centre.
Welcome to the third New Zealand Food Safety Science Research Centres NZFSSRC newsletter where we celebrate the work of our researchers students and industry partners. Want the latest from us. We recognise the importance of involving all stakeholders together throughout the lifetime of the Centre.
Palmerston North Convention Centre Main Street PN. It is a virtual centre that will see the best scientists from around the country collaborating on work. NZIFST Fellowships Awards.
Our research looks at the whole food system. Formed as a partnership between government industry organisations and research institutions the centre aims to ensure New Zealands food safety system remains among the best in the world. The report was first published in March 2020 and updated in mid-April version 2 mid-May version 3 July version 4 and December 2020 version 5.
The New Zealand Food Safety Science and Research Centre was launched last week in Palmerston North. New Zealand Food Safety Science Research Centre Email. Formed as a partnership between government industry organisations and research institutions the centre aims to ensure New Zealands food safety system remains among the best in the world.
Science and Innovation Minister Steven Joyce and Food Safety Minister Nikki Kaye today announced that expressions of interest have been released for a Food Safety Science and Research Centre. Formed as a partnership between government industry organisations and research institutions the virtual centre aims to ensure New Zealands food safety system remains among the. Science and Innovation Minister Steven Joyce and Food Safety Minister JoGoodhew today launched the New Zealand Food Safety Science and Research Centre at Massey University in Palmerston North.
With the help of the industry participants we have completed the first round of sector workshops. Science and Innovation Minister Steven Joyce and Food Safety Minister JoGoodhew today launched the New Zealand Food Safety Science and Research Centre at Massey University in Palmerston North. These were aimed at understanding food safety research needs from an industry perspective.
Newsletter The purpose of this newsletter is to provide you with a brief update on progress with the establishment of the New Zealand Food Safety Science and Research Centre the Centre.

Special Issue Food Security And Food Sciences By Aftnsoj To Know More Http Openventio Org Advancesinfoodtechnol Food Science Food Security Food Technology

Postgraduate Study In Food Science The University Of Auckland

Food New Zealand December 2019 January2020 Issue By Nz Institute Of Food Science And Technology Issuu

Buy Massey University Fake Diplomas Get Bachelor Degree Online Fakeadiploma Com University Diploma Bachelors Degree Diploma

Pin By Bryan Shane On Medical Food Food Additives Types Of Bread

Iiser Kolkata Research Fellow Jobs Junior Research Fellow Vacancy For Candidates With Background In Biology Iiser Biology Jobs Indian Institute Of Science Msc

Microplastics Research Learning Science Ministry Of Education Online Newsletter

Postgraduate Study In Wine Science The University Of Auckland

Master Of Food Technology Massey University

Food New Zealand Magazine Of The Nz Institute Of Food Science And Technology By Nz Institute Of Food Science And Technology Issuu

Joint Graduate School In Plant And Food Science The University Of Auckland

Post a Comment for "New Zealand Food Safety Science And Research Centre"